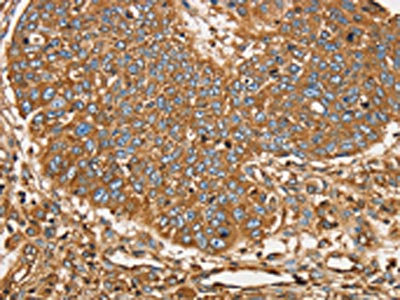

SCD Antibody
-
中文名稱:SCD兔多克隆抗體
-
貨號:CSB-PA256001
-
規(guī)格:¥1100
-
圖片:
-
The image on the left is immunohistochemistry of paraffin-embedded Human lung cancer tissue using CSB-PA256001(SCD Antibody) at dilution 1/25, on the right is treated with synthetic peptide. (Original magnification: ×200)
-
The image on the left is immunohistochemistry of paraffin-embedded Human brain tissue using CSB-PA256001(SCD Antibody) at dilution 1/25, on the right is treated with synthetic peptide. (Original magnification: ×200)
-
-
其他:
產(chǎn)品詳情
-
Uniprot No.:
-
基因名:
-
別名:SCD; FADS5; SCD1; SCDOS; Stearoyl-CoA desaturase; hSCD1; Acyl-CoA desaturase; Delta(9-desaturase; Delta-9 desaturase; Fatty acid desaturase
-
宿主:Rabbit
-
反應(yīng)種屬:Human
-
免疫原:Synthetic peptide of Human SCD
-
免疫原種屬:Homo sapiens (Human)
-
標記方式:Non-conjugated
-
抗體亞型:IgG
-
純化方式:Antigen affinity purification
-
濃度:It differs from different batches. Please contact us to confirm it.
-
保存緩沖液:-20°C, pH7.4 PBS, 0.05% NaN3, 40% Glycerol
-
產(chǎn)品提供形式:Liquid
-
應(yīng)用范圍:ELISA,IHC
-
推薦稀釋比:
Application Recommended Dilution ELISA 1:1000-1:2000 IHC 1:25-1:100 -
Protocols:
-
儲存條件:Upon receipt, store at -20°C or -80°C. Avoid repeated freeze.
-
貨期:Basically, we can dispatch the products out in 1-3 working days after receiving your orders. Delivery time maybe differs from different purchasing way or location, please kindly consult your local distributors for specific delivery time.
-
用途:For Research Use Only. Not for use in diagnostic or therapeutic procedures.
相關(guān)產(chǎn)品
靶點詳情
-
功能:Stearoyl-CoA desaturase that utilizes O(2) and electrons from reduced cytochrome b5 to introduce the first double bond into saturated fatty acyl-CoA substrates. Catalyzes the insertion of a cis double bond at the delta-9 position into fatty acyl-CoA substrates including palmitoyl-CoA and stearoyl-CoA. Gives rise to a mixture of 16:1 and 18:1 unsaturated fatty acids. Plays an important role in lipid biosynthesis. Plays an important role in regulating the expression of genes that are involved in lipogenesis and in regulating mitochondrial fatty acid oxidation. Plays an important role in body energy homeostasis. Contributes to the biosynthesis of membrane phospholipids, cholesterol esters and triglycerides.
-
基因功能參考文獻:
- Study results suggest that stearoyl-coenzyme A desaturase 1 activity is required for cumulus cell lipid storage and steroidogenesis. PMID: 28345489
- study has provided evidence supporting the potential role of SCD1 as a biomarker for human bladder cancer prognosis. PMID: 29396722
- SCD1 overexpression was found in Hepatocellular Carcinomas , which was associated with shorter disease-free survival. PMID: 28647567
- Experimental models in mice and human epithelial cells suggest that inhibition of stearoyl-coenzyme A desaturase activity leads to airway hyper-responsiveness and reduced antiviral defense. PMID: 28397284
- alterations in leptin and SCD-1 in HCU patients PMID: 28801090
- CD36, also known as FA translocase (FAT), that functions as a transmembrane protein and mediates the uptake of FAs, is observed to be highly expressed in breast cancer tissues. Furthermore, the anti-proliferation effect caused by the SCD1 inhibitor can not be reversed by exogenous oleic acid supplementation in CD36 knockdown breast cancer cells PMID: 28765876
- Our findings suggested that SCD1 plays a key role in the pathophysiology of leptin resistance in neuronal cells associated with obesity. PMID: 28768997
- high expression of SCD1 is more frequently observed in late stage lung adenocarcinoma patients and presents poor prognosis PMID: 27223066
- Our results suggest that relatively common genetic variants in stearoyl CoA desaturase and SREBF1 attenuated the positive associations between intake of a traditional diet rich in n-3 polyunsaturated fatty acids and increases in fasting cholesterol and HbA1c levels, as well as the waist-to-hip ratio among Yup'ik participants. PMID: 27467133
- Results provide evidence that SCD is a regulator of breast stemness. PMID: 27306423
- these data demonstrate for the first time the involvement of SCD1 in the regulation of the Hippo pathway in lung cancer, and point to fatty acids metabolism as a key regulator of lung cancer stem cells. PMID: 28368399
- High SCD1 expression is associated with resistance to cisplatin in lung cancer. PMID: 28797843
- Results provide evidence that the hepatic BSCL2 deficiency induces the increase and expansion of lipid droplets potentially via increased SCD1 activity. PMID: 27838812
- high SCD1 expression is an independent prognostic factor for OS in patients with ccRCC. Our data suggest that the expression of SCD1 might guide the clinical decisions for patients with ccRCC. PMID: 27861513
- A relevant link between one-night sleep deprivation , hepatic SCD1 expression and de-novo fatty acid synthesis via epigenetically driven regulatory mechanisms was found. PMID: 27562731
- stearoyl-coenzyme A desaturase 1 has a role in clear cell renal cell carcinoma PMID: 26224474
- Chronic exposure to chewing tobacco induces carcinogenesis in non-malignant oral epithelial cells and SCD plays an essential role in this process. PMID: 26391970
- This study illustrates for the first time that, in contrast to hepatic and adipose tissue, estrogen induces SCD-1 expression and activity in breast carcinoma cells. These results support SCD-1 as a therapeutic target in estrogen-sensitive breast cancer. PMID: 26022099
- The data indicate a direct inhibitory interaction of polyunsaturated fatty acids with LXRalpha, a consequent reduction of SREBP-1 and of its binding to SCD1 promoter. PMID: 25264165
- Both siRNA-mediated and pharmacological inhibition of SCD1 impaired tumor cells migration. PMID: 25880005
- SCD1 is found upregulated upon renal cell transformation indicating that its activity, while not impacting proliferation, represents a critical bottleneck for tumourigenesis PMID: 24769897
- SCD1 negatively regulates autophagy-induced cell death in human hepatocellular carcinoma through inactivation of the AMPK signaling pathway. PMID: 25528629
- An association with Graves ophthalmopathy was shown for SNP rs1393491 in SCD. PMID: 24780075
- Stearoyl-CoA desaturase is encoded by an SCD gene, which, depending on the species, may exist as different isoforms. (review) PMID: 24864084
- DNA methylation levels of the SCD1 promoter were associated with weight change and with adherence to a Mediterranean diet. PMID: 24827925
- These data further support the idea that SCD1 is associated with hepatitis C virus replication complex and that its products may contribute to the proper formation and maintenance of membranous web structures during virus replication. PMID: 25122791
- These results demonstrate that cardiometabolic risk factors are modulated by genetic variations in the SCD1 gene alone or in combination with n-3 polyunsaturated fatty acid supplementation. PMID: 24375980
- Genetic variation of the SCD1 gene may contribute to the risk of obesity, interacting with the type of dietary fat. PMID: 23934750
- The effect of fenretinide on stearoyl-CoA desaturase should be considered in its potential therapeutic role against cancer, type-2 diabetes, and retinal diseases. PMID: 24357007
- The results suggest that SCD1 is a critical target in lung cancer tumor-initiating cells. PMID: 24309934
- genetic association studies in population of men in Sweden: Data suggest that SNPs in SCD1 are associated with cancer death, especially among men with low intake of dietary polyunsaturated fatty acids. PMID: 24368438
- This minireview summarizes the role of skin SCD1 in regulating skin integrity and whole body energy homeostasis and offers a discussion of potential pathways that may connect these seemingly disparate phenotypes. PMID: 24356954
- SCD was strongly expressed in surgically resected hepatocellular carcinoma (HCC) (n = 64) and various human HCC cell lines PMID: 24135379
- Human breast cancer tissues contain abundant phosphatidylcholine(36ratio1) with high stearoyl-CoA desaturase-1 expression. PMID: 23613812
- Increased SCD1 expression supports clear cell renal cell carcinoma cell viability. PMID: 23633458
- Patients with primary breast cancers expressing high SCD1 levels had significantly shorter relapse-free survival and overall survival in multivariable analysis. PMID: 23208590
- Both SCD1 and HIF-2alpha are critical to promoting tumorigenesis by synergistically acting on maintaining cell survival, triggering cell migration, and enhancing the colony formation ability of ca PMID: 23331615
- In a large community-based prospective cohort study, the estimate of SCD-1 activity by SCD16c had the strongest association with incident diabetes. PMID: 22819528
- There are no associations between common variants of SCD1 or its inferred haplotypes and the investigated metabolic risk factors. PMID: 23139775
- In human bladder cancer cell lines expressing constitutively active FGFR3, knockdown of SCD1 by siRNA markedly attenuated cell-cycle progression, reduced proliferation, and induced apoptosis. PMID: 23019225
- findings show low SCD1 expression is linked to a decrease in proliferation rate of breast cancer cells; this was accompanied by an increase in GSK3 activity; nuclear translocation of beta-catenin was decreased and its transactivation capacity; this suggests a role of SCD1 in EMT and cancer progression PMID: 23013158
- Thyroid hormone negatively regulates human SCD-1 gene expression in without direct binding of the TH receptor to the SCD-1 gene promoter. PMID: 23221600
- The individual hepatic SCD1 activity is a determinant of liver fat accumulation under lipogenic dietary conditions. PMID: 23015656
- data indicate that SCD activity may control lung cancer cell metabolism, proliferation and survival by modulating the EGFR-->Akt/ERK signaling platforms PMID: 22946088
- study showed cystic fibrosis cells exhibit increased metabolism along metabolic pathways leading to n-7 and n-9 fatty acids compared with wild-type cells; changes are accompanied by increased expression of Delta5, Delta6 and Delta9 desaturases and elongases 5 and 6 PMID: 21544602
- The mRNA levels of LXRalpha and SREBP-1c, transcription factors that regulate SCD-1, were decreased by 10,12 conjugated linoleic acid in human adipocytes. PMID: 21775116
- data outline an effective strategy to establish an unambiguous link between fatty acid synthesis and cancer cell survival, and point toward SCD1 as a key target in this pathway PMID: 22457791
- SCD1 activity and genetic variation have an important role in modulating the relationship between fatty acids and inflammation in young adults PMID: 22209225
- Repression of SCD1 by alpha-linolenic acid favorably increased cholesterol efflux and decreased cholesterol accumulation in foam cells. PMID: 21658928
- [review] muscle. This review evaluates the role of SCD-1 as a homeostatic check-point between glucose and fatty acid metabolism in the development and progression of obesity. PMID: 21831035
顯示更多
收起更多
-
亞細胞定位:Endoplasmic reticulum membrane; Multi-pass membrane protein.
-
蛋白家族:Fatty acid desaturase type 1 family
-
組織特異性:Detected in fetal liver, lung and brain. Highly expressed in adult adipose tissue, and at lower levels in adult brain and lung.
-
數(shù)據(jù)庫鏈接:
Most popular with customers
-
-
Phospho-YAP1 (S127) Recombinant Monoclonal Antibody
Applications: ELISA, WB, IHC
Species Reactivity: Human
-
-
-
-
-
-